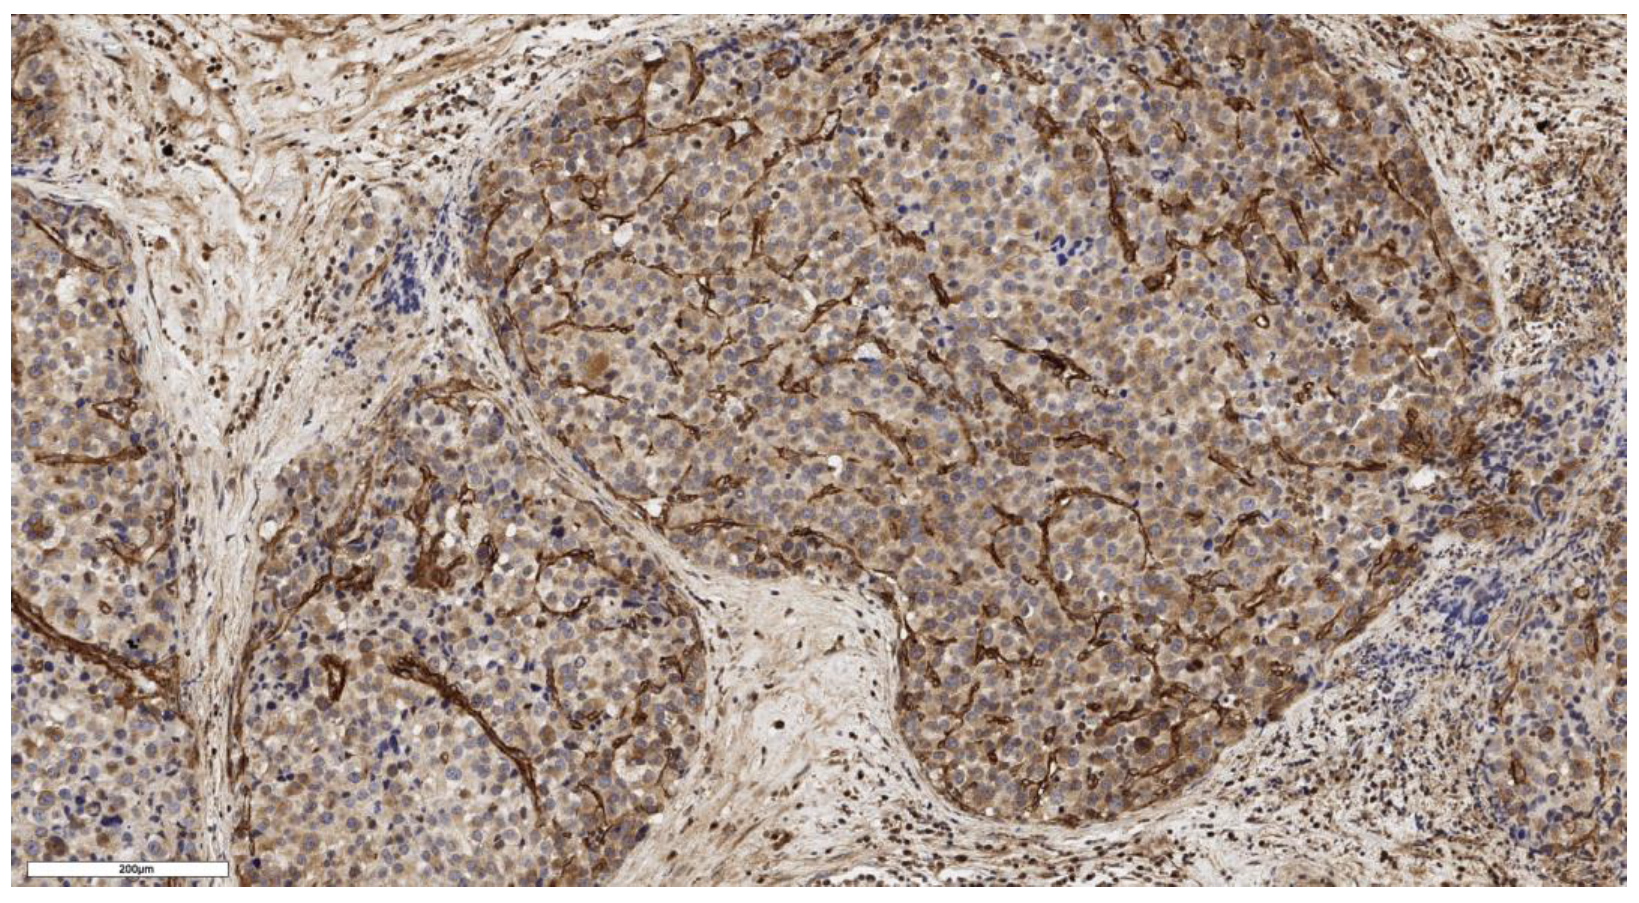
Cimb 46 00825 g004

Analysis of Cancer Stem Cell Markers in Various Histological Subtypes of Adrenocortical Cancer
Abstract
:1. Introduction
2. Materials and Methods
2.1. Patients and Samples
2.2. Immunohistochemistry Imaging
2.3. Statistical Analysis
3. Results
3.1. Analysis of CD90 Marker Expression
3.2. Analysis of LGR5 Marker Expression
3.3. Analysis of Patient Survival Depending on the Expression of Stem Markers
3.4. Analysis of Stem Marker Expression in Normal Adrenal Tissue
4. Discussion
5. Conclusions
Author Contributions
Funding
Institutional Review Board Statement
Informed Consent Statement
Data Availability Statement
Conflicts of Interest
References
- Grabek, A.; Dolfi, B.; Klein, B.; Jian-Motamedi, F.; Chaboissier, M.C.; Schedl, A. The Adult Adrenal Cortex Undergoes Rapid Tissue Renewal in a Sex-Specific Manner. Cell Stem Cell 2019, 25, 290–296.e2. [Google Scholar] [CrossRef] [PubMed]
- Mariniello, K.; Ruiz-Babot, G.; McGaugh, E.C.; Nicholson, J.G.; Gualtieri, A.; Gaston-Massuet, C.; Nostro, M.C.; Guasti, L. Stem Cells, Self-Renewal, and Lineage Commitment in the Endocrine System. Front. Endocrinol. 2019, 10, 772. [Google Scholar] [CrossRef] [PubMed]
- Hammer, G.D.; Basham, K.J. Stem cell function and plasticity in the normal physiology of the adrenal cortex. Mol. Cell. Endocrinol. 2021, 519, 111043. [Google Scholar] [CrossRef] [PubMed]
- Lyraki, R.; Schedl, A. Adrenal cortex renewal in health and disease. Nat. Rev. Endocrinol. 2021, 17, 421–434. [Google Scholar] [CrossRef] [PubMed]
- Oikonomakos, I.; Weerasinghe Arachchige, L.C.; Schedl, A. Developmental mechanisms of adrenal cortex formation and their links with adult progenitor populations. Mol. Cell. Endocrinol. 2021, 524, 111172. [Google Scholar] [CrossRef]
- Pignatti, E.; Flück, C.E. Adrenal cortex development and related disorders leading to adrenal insufficiency. Mol. Cell. Endocrinol. 2021, 527, 111206. [Google Scholar] [CrossRef]
- Clevers, H. The cancer stem cell: Premises, promises and challenges. Nat. Med. 2011, 17, 313–319. [Google Scholar] [CrossRef]
- López-Lázaro, M. The stem cell division theory of cancer. Cell Cycle 2018, 123, 95–113. [Google Scholar] [CrossRef]
- Siegel, R.L.; Miller, K.D.; Wagle, N.S.; Jemal, A. Cancer statistics, 2023. CA Cancer J. Clin. 2023, 73, 17–48. [Google Scholar] [CrossRef]
- Clarke, M.F. Clinical and Therapeutic Implications of Cancer Stem Cells. N. Engl. J. Med. 2019, 380, 2237–2245. [Google Scholar] [CrossRef]
- Reya, T.; Morrison, S.J.; Clarke, M.F.; Weissman, I.L. Stem cells, cancer, and cancer stem cells. Nature 2001, 414, 105–111. [Google Scholar] [CrossRef] [PubMed]
- Walcher, L.; Kistenmacher, A.K.; Suo, H.; Kitte, R.; Dluczek, S.; Strauß, A.; Blaudszun, A.R.; Yevsa, T.; Fricke, S.; Kossatz-Boehlert, U. Cancer Stem Cells—Origins and Biomarkers: Perspectives for Targeted Personalized Therapies. Front. Immunol. 2020, 11, 1280. [Google Scholar] [CrossRef] [PubMed]
- Zhao, W.; Li, Y.; Zhang, X. Stemness-Related Markers in Cancer. Cancer Transl. Med. 2017, 3, 87–95. [Google Scholar] [CrossRef] [PubMed]
- Zhao, W.; Ji, X.; Zhang, F.; Li, L.; Ma, L. Embryonic Stem Cell Markers. Molecules 2012, 17, 6196–6236. [Google Scholar] [CrossRef]
- Barker, N.; van Es, J.H.; Kuipers, J.; Kujala, P.; van den Born, M.; Cozijnsen, M.; Haegebarth, A.; Korving, J.; Begthel, H.; Peters, P.J.; et al. Identification of stem cells in small intestine and colon by marker gene Lgr5. Nature 2007, 449, 1003–1007. [Google Scholar] [CrossRef]
- Al-Kharusi, M.R.; Smartt, H.J.; Greenhough, A.; Collard, T.J.; Emery, E.D.; Williams, A.C.; Paraskeva, C. LGR5 promotes survival in human colorectal adenoma cells and is upregulated by PGE2: Implications for targeting adenoma stem cells with NSAIDs. Carcinogenesis 2013, 34, 1150–1157. [Google Scholar] [CrossRef]
- McClanahan, T.; Koseoglu, S.; Smith, K.; Grein, J.; Gustafson, E.; Black, S.; Kirschmeier, P.; Samatar, A.A. Identification of overexpression of orphan G protein-coupled receptor GPR49 in human colon and ovarian primary tumors. Cancer Biol. Ther. 2006, 5, 419–426. [Google Scholar] [CrossRef]
- Little, D.W.; Dumontet, T.; LaPensee, C.R.; Hammer, G.D. β-catenin in adrenal zonation and disease. Mol. Cell. Endocrinol. 2021, 522, 111120. [Google Scholar] [CrossRef]
- Al-bedhawi, M. Identification and Characterisation of a Potential Adrenocortical Stem Cell Population; University of Reading: Reading, UK, 2018. [Google Scholar]
- Dominici, M.; Le Blanc, K.; Mueller, I.; Slaper-Cortenbach, I.; Marini, F.; Krause, D.; Deans, R.; Keating, A.; Prockop, D.J.; Horwitz, E. Minimal criteria for defining multipotent mesenchymal stromal cells. The International Society for Cellular Therapy position statement. Cytotherapy 2006, 8, 315–317. [Google Scholar] [CrossRef]
- Rindi, G.; Mete, O.; Uccella, S.; Basturk, O.; La Rosa, S.; Brosens, L.A.A.; Ezzat, S.; de Herder, W.W.; Klimstra, D.S.; Papotti, M.; et al. Overview of the 2022 WHO Classification of Neuroendocrine Neoplasms. Endocr. Pathol. 2022, 33, 115–154. [Google Scholar] [CrossRef]
- Chandrasekar, T.; Goldberg, H.; Klaassen, Z.; Wallis, C.J.D.; Woon, D.T.S.; Herrera-Caceres, J.O.; Kulkarni, G.S.; Fleshner, N.E. The who, when, and why of primary adrenal malignancies: Insights into the epidemiology of a rare clinical entity. Cancer 2019, 125, 1050–1059. [Google Scholar] [CrossRef] [PubMed]
- Fassnacht, M.; Dekkers, O.M.; Else, T.; Baudin, E.; Berruti, A.; de Krijger, R.R.; Haak, H.R.; Mihai, R.; Assie, G.; Terzolo, M. European Society of Endocrinology Clinical Practice Guidelines on the management of adrenocortical carcinoma in adults, in collaboration with the European Network for the Study of Adrenal Tumors. Eur. J. Endocrinol. 2018, 179, G1–G46. [Google Scholar] [CrossRef] [PubMed]
- Li, Y.R.; Fang, Y.; Lyu, Z.; Zhu, Y.; Yang, L. Exploring the dynamic interplay between cancer stem cells and the tumor microenvironment: Implications for novel therapeutic strategies. J. Transl. Med. 2023, 21, 686. [Google Scholar] [CrossRef] [PubMed]
- Shu, X.; Liu, H.; Pan, Y.; Sun, L.; Yu, L.; Sun, L.; Yang, Z.; Ran, Y. Distinct biological characterization of the CD44 and CD90 phenotypes of cancer stem cells in gastric cancer cell lines. Mol. Cell. Biochem. 2019, 459, 35–47. [Google Scholar] [CrossRef] [PubMed]
- Leung, C.; Tan, S.H.; Barker, N. Recent Advances in Lgr5+ Stem Cell Research. Trends Cell Biol. 2018, 28, 380–391. [Google Scholar] [CrossRef]
- Ohta, Y.; Fujii, M.; Takahashi, S.; Takano, A.; Nanki, K.; Matano, M.; Hanyu, H.; Saito, M.; Shimokawa, M.; Nishikori, S.; et al. Cell-matrix interface regulates dormancy in human colon cancer stem cells. Nature 2022, 608, 784–794. [Google Scholar] [CrossRef]
- Sato, T.; Vries, R.G.; Snippert, H.J.; van de Wetering, M.; Barker, N.; Stange, D.E.; van Es, J.H.; Abo, A.; Kujala, P.; Peters, P.J.; et al. Single Lgr5 stem cells build crypt-villus structures in vitro without a mesenchymal niche. Nature 2009, 459, 262–265. [Google Scholar] [CrossRef]
- Sato, T.; Stange, D.E.; Ferrante, M.; Vries, R.G.; Van Es, J.H.; Van den Brink, S.; Van Houdt, W.J.; Pronk, A.; Van Gorp, J.; Siersema, P.D.; et al. Long-term expansion of epithelial organoids from human colon, adenoma, adenocarcinoma, and Barrett’s epithelium. Gastroenterology 2011, 141, 1762–1772. [Google Scholar] [CrossRef]
- Driehuis, E.; Kretzschmar, K.; Clevers, H. Establishment of patient-derived cancer organoids for drug-screening applications. Nat. Protoc. 2020, 15, 3380–3409. [Google Scholar] [CrossRef]
- Fujii, M.; Shimokawa, M.; Date, S.; Takano, A.; Matano, M.; Nanki, K.; Ohta, Y.; Toshimitsu, K.; Nakazato, Y.; Kawasaki, K.; et al. A Colorectal Tumor Organoid Library Demonstrates Progressive Loss of Niche Factor Requirements during Tumorigenesis. Cell Stem Cell 2016, 18, 827–838. [Google Scholar] [CrossRef]
- Koh, H.M.; Lee, H.J.; Kim, D.C. Prognostic and clinicopathological value of CD90 expression in cancer patients: A systematic review and meta-analysis. Transl. Cancer Res. 2021, 10, 3356–3363. [Google Scholar] [CrossRef] [PubMed]
- Hu, Y.; Jin, D.; Zhou, Y.; Cheng, Y.; Cao, H.; Ma, Y.; Zhang, W. Multiple roles of THY1 in gastric cancer based on data mining. Transl. Cancer Res. 2020, 9, 2748–2757. [Google Scholar] [CrossRef] [PubMed]

| Sign | N | Me [Q1; Q3] |
|---|---|---|
| Age, years | 13 | 54 [37; 59] |
| Tumor size, cm | 13 | 8 [5; 9,5] |
| Ki-67 proliferative index, % | 13 | 15 [10; 25] |
| Conventional subtype | 3 | 20 [15; 60] |
| Oncocytic subtype | 3 | 10 [5; 15] |
| Myxoid subtype | 3 | 10 [7; 20] |
| Mixed (conventional + myxoid) subtype | 4 | 27.5 [10; 60] |
| DFS, months | 13 | 16 [2; 32] |
| OS, months | 13 | 20 [16; 34] |
| Sign | N | % |
| T stage | ||
| T1 | 4 | 30.8 |
| T2 | 4 | 30.8 |
| T3 | 4 | 30.8 |
| T4 | 1 | 7.7 |
| N stage | ||
| N0 | 10 | 76.9 |
| N1 | 3 | 23.1 |
| M stage | ||
| M0 | 11 | 85.0 |
| M1 | 2 | 15.0 |
| ENSAT | ||
| I | 4 | 30.8 |
| II | 4 | 30.8 |
| III | 3 | 23.0 |
| IV | 2 | 15.4 |
| Hormonal activity of the tumor | ||
| Non-functional | 8 | 61.5 |
| Hypercorticism | 2 | 15.4 |
| Hyperaldosteronism | 1 | 7.7 |
| Hypercorticism and hyperaldosteronism | 2 | 15.4 |
| Histological subtypes of ACC | ||
| Conventional | 3 | 23.0 |
| Oncocytic | 3 | 23.0 |
| Myxoid | 3 | 23.0 |
| Mixed (conventional + myxoid) | 4 | 30.8 |
| Sign | Conventional Subtype | Oncocytic Subtype | Myxoid Subtype | Mixed Subtype | p-Value | ||||
|---|---|---|---|---|---|---|---|---|---|
| Number of CD90+ cells beneath the tumor capsule, cells/mm2 | N | Values | N | Values | N | Values | N | Values | 0.163 |
| 3 | 91; 118; 21 | 3 | 18; 91; 139 | 3 | 6; 3; 10 | 4 | 57; 204; 4; 26 | ||
| Number of CD90+ cells in the tumor parenchyma, cells/mm2 | N | Values | N | Values | N | Values | N | Values | 0.161 |
| 3 | 207; 230; 160 | 3 | 16; 0; 156 | 3 | 5; 13; 20 | 4 | 28; 621; 5; 320 | ||
| Sign | Conventional Subtype | Oncocytic Subtype | Myxoid Subtype | Mixed Subtype | p-Value | ||||
|---|---|---|---|---|---|---|---|---|---|
| Expression of the LGR5 marker in scores | N | Values | N | Values | N | Values | N | Values | 0.199 |
| 3 | 3; 1; 2 | 3 | 2; 3; 2 | 3 | 1; 1; 1 | 4 | 2; 1; 1; 3 | ||
Disclaimer/Publisher’s Note: The statements, opinions and data contained in all publications are solely those of the individual author(s) and contributor(s) and not of MDPI and/or the editor(s). MDPI and/or the editor(s) disclaim responsibility for any injury to people or property resulting from any ideas, methods, instructions or products referred to in the content. |
© 2024 by the authors. Licensee MDPI, Basel, Switzerland. This article is an open access article distributed under the terms and conditions of the Creative Commons Attribution (CC BY) license (https://creativecommons.org/licenses/by/4.0/).
Share and Cite
Pachuashvili, N.; Bastrich, A.; Porubayeva, E.; Elfimova, A.; Tertychnyy, A.; Beltsevich, D.; Kogan, E.; Reshetov, I.; Troshina, E.; Tarbaeva, N.; et al. Analysis of Cancer Stem Cell Markers in Various Histological Subtypes of Adrenocortical Cancer. Curr. Issues Mol. Biol. 2024, 46, 13798-13810. https://doi.org/10.3390/cimb46120825
Pachuashvili N, Bastrich A, Porubayeva E, Elfimova A, Tertychnyy A, Beltsevich D, Kogan E, Reshetov I, Troshina E, Tarbaeva N, et al. Analysis of Cancer Stem Cell Markers in Various Histological Subtypes of Adrenocortical Cancer. Current Issues in Molecular Biology. 2024; 46(12):13798-13810. https://doi.org/10.3390/cimb46120825
Chicago/Turabian StylePachuashvili, Nano, Asya Bastrich, Erika Porubayeva, Alina Elfimova, Alexander Tertychnyy, Dmitry Beltsevich, Evgeniya Kogan, Igor Reshetov, Ekaterina Troshina, Natalia Tarbaeva, and et al. 2024. "Analysis of Cancer Stem Cell Markers in Various Histological Subtypes of Adrenocortical Cancer" Current Issues in Molecular Biology 46, no. 12: 13798-13810. https://doi.org/10.3390/cimb46120825
APA StylePachuashvili, N., Bastrich, A., Porubayeva, E., Elfimova, A., Tertychnyy, A., Beltsevich, D., Kogan, E., Reshetov, I., Troshina, E., Tarbaeva, N., Mokrysheva, N., & Urusova, L. (2024). Analysis of Cancer Stem Cell Markers in Various Histological Subtypes of Adrenocortical Cancer. Current Issues in Molecular Biology, 46(12), 13798-13810. https://doi.org/10.3390/cimb46120825






